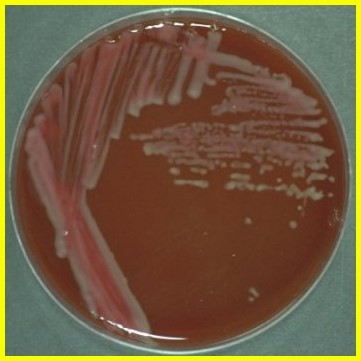
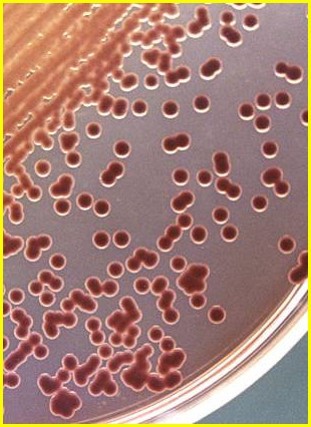
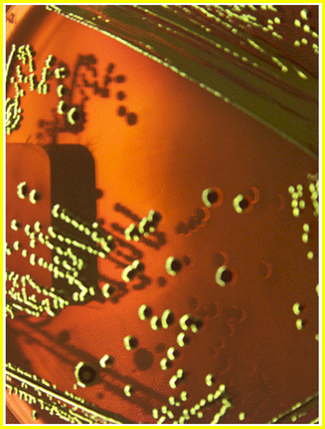

All of the Enterobacteriaceae appear as _____ on gram staining?
Gram negative rods
What component of the Enterobacteriaceae contributes to septic shock?
LPS
T/F Enterobacteriaceae are obligate anaerobes
FALSE Enterobacteriaceae are facultative anaerobes
When grown anaerobcally, enterobacteriaceae ferment _____
Glucose
What test distinguishes enterobacteriaceae from Pseudomonas?
Oxidase test Reagent remains colorless with enterobacteriaceae, turns colors with pseudomonas
What three surface antigens are used for typing of Enterobacteriaceae?
In septic shock caused by Enterobacteriaceae, bacterial LPS binds _____, causing generation of pro-inflammatory cytokines
CD14 of macrophages
T/F The presence of 20+ PMN per HPF implies the patient has an inflammatory diarrhea (Shigella)
TRUE
Few or no fecal leukocytes is seen in watery diarrheas (toxigenic cholera/viral)
On blood agar, Enterobacteriaceae appear as _____
Gray, mucoid colonies
What are the three treatment options for Traveler’s Diarrhea?
Note: these do not cure the condition, but they shorten the duration of symptoms. Thus, fluid and electrolyte replacement is suggested to prevent bacterial resistance.
Many of the Enterobacteriaceae ferment _____
Lactose
What special agar is used to culture E. coli? How does it look.
E. coli hydrolyzes tryptophan to _____
Indole (positive indole test)

On Eosin Methylene Blue (EMB), E. coli makes acid and creates a _____
Green sheen
Enterotoxigenic E. Coli (ETEC) is transmitted ______, and commonly causes _____.
T/F ETEC invades epithelial cells
FALSE
ETEC only adheres to small intestine via its pili (colonization factor antigens - CFA1 & CFA2)
ETEC stimulates _____ and _____ causing hypersecretion of electrolytes
What are the two toxins secreted by ETEC?
_____ E. coli starts off with a watery diarry that eventually becomes bloody and watery
Enteroinvasive E. coli (EIEC)
Treatment for EIEC?
Same as ETEC (Fluoroquinolone, Rifaximin, azithromycin)
What are the symptoms of EIEC?
What is the main reservoir of EHEC?
Cattle
EHEC makes _____ toxin. What does it do?
What occurs when shiga toxin damages blood vessels in the epithelium of glomeruli, with resultant in kidney failure and thrombocytopenia leading to renal failure, neuro. deficits (5-10%), and death (5-10%). What populations does this condition usually effect? How is it treated?